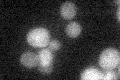
YAL049C
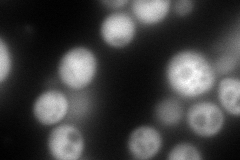
YAL049C
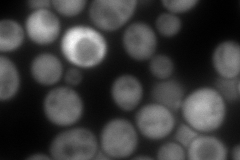
YAL049C
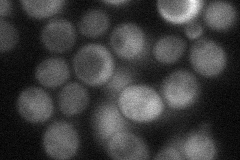
YAL049C
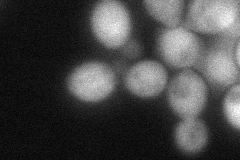
YAL049C
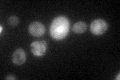
YAL049C

View description
Cytoplasmic protein involved in mitochondrial function or organization; null mutant displays reduced frequency of mitochondrial genome loss; potential Hsp82p interactor
Localization:
Intensity:
Fold change:
Significance:
-
C’ GFP library in SD
below threshold18.42 -
N' NOP1pr-GFP in SD
cytosol260.528 -
N' TEF2pr-mCherry in SD
cytosol352.906 -
N' NATIVEpr-GFP in SD
cytosol29.7075 -
N' TEF2pr-VC and Cyto-VN in SD
cytosol72.256 -
C’ GFP library in SD+DTT

cytosol28.281.53No -
C’ GFP library in SD+H2O2

cytosol18.491No -
C’ GFP library in Starvation Media
cytosol89.554.85No -
C’ GFP library on the background of Pup2-DaMP

below threshold -
C’ GFP library on the background of CCT mutant

below threshold17.83470.967775No
